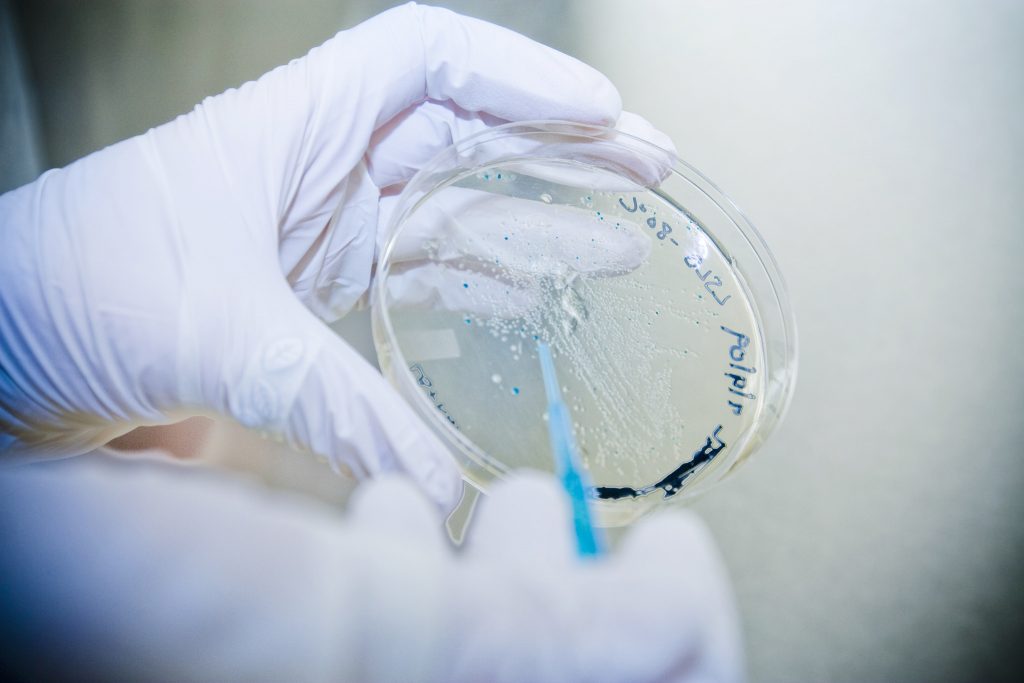
Корейские ученые впервые нашли вещество, которое вызывает рак Корейские ученые впервые нашли вещество, которое вызывает рак

Наука и техника — открытия, исследования, технологии
08 июля 2017 в 12:37
08 июля 2017
12 : 37
08 июля 2017 в 12:34
08 июля 2017
12 : 34
08 июля 2017 в 10:56
08 июля 2017
10 : 56
08 июля 2017 в 10:50
08 июля 2017
10 : 50
06 июля 2017 в 10:05
06 июля 2017
10 : 05
04 июля 2017 в 10:03
04 июля 2017
10 : 03
04 июля 2017 в 09:52
04 июля 2017
09 : 52
04 июля 2017 в 09:50
04 июля 2017
09 : 50
04 июля 2017 в 09:47
04 июля 2017
09 : 47
20 апреля 2017 в 09:50
20 апреля 2017
09 : 50
27 марта 2017 в 16:08
27 марта 2017
16 : 08
24 марта 2017 в 12:03
24 марта 2017
12 : 03
20 марта 2017 в 14:25
20 марта 2017
14 : 25
19 марта 2017 в 00:10
19 марта 2017
00 : 10